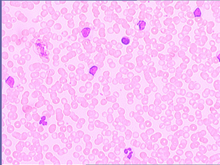
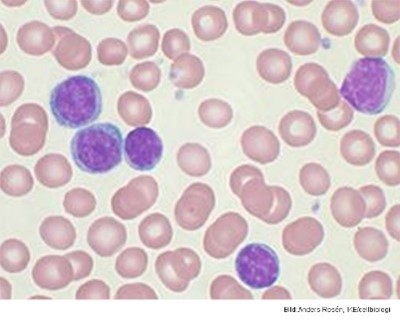

Varför kallas sjukdomen som Epstein Barr-viruset ger upphov till för mononukleos?
Hur aktiveras cytokiner vid mononukleos och vad leder de till?
Vad visar bilden?

Hur undkommer EBV NK, CD4+ och CD8+ T-celler och varför kan det aktiveras på nytt?
Varför är EBV är ett bra exempel på transformerande onkogena virus?
Virala proteiner ingriper bland annat i det cellcykelkontrollerande Rb (retinoblastomproteinet).
Vad tyder detta på?

Vad tyder detta på?

Vad är ett koagulastest?

Vad är Dnas?
Hur görs ett DNas-test?

Vilken specifik bakterie kan detta vara?

Escherichia Coli
Stor risk att detta är? Som beror på?
Urinvägsinfektion som beror på Escherichia coli
Lungröntgen av hostande patient:
Tuberkulos
Vad visar bilden?


Trött here (53 år) med svullna lymfkörtlar ljumske. Trombocyter låga och leukocyter mkt högt.
Vad tror du ett blodutstryk visar om det vill sig illa?

Små mogna blaster i överflöd (ja de ska ju inte finnas där), detta tyder på någon typ av lymfatisk leukemi
Förklara DAT, flödescytometrin och IGHV-sekvensen

Akutmottagningen med en 9-årig flicka. På ett födelsedagskalas har hon fått kliande utslag över hela kroppen. Hon blev snabbt blek, illamående och kräktes. Framme vid akutmottagningen rapporterar ambulanspersonalen att flickan, som heter Gabriella Ring, har varit takykard, snabbandad och krävt två liter syrgas för att hålla transkutan syrgasmättnad på 96%.
Vad kan detta handla om?
Anafylaktisk reaktion
Vilken behandling kan vara lämplig vid en anafylaktisk chock?
Etina söker nu vårdcentralen pga. uttalad värk och ömhet i höger fots MTP-led V. Besvären började för c:a 2 veckor sedan. Hon har provat värktabletter (paracetamol), men tycker inte att det hjälpt nämnvärt. Sedan tonåren röker hon ca 10-15 cigaretter om dagen och tar gärna ett glas vin till middagen. Fysisk aktivitet inskränker sig till promenader då och då.
Vad har Etina eventuellt drabbats av?
RA
Vad har denna patient troligen drabbats av?

RA
Ses något patologiskt?


Vätska och inflammationsceller ansamlas i synovium och skapar en förtjockad synovialvävnad
Pannus
Vad bör alltid (utan undantag) en person som drabbats av RA göra?
Sluta röka!